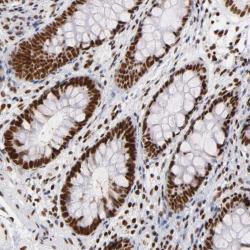

Antibody data
- Antibody Data
- Antigen structure
- References [5]
- Comments [0]
- Validations
- Western blot [1]
- Immunohistochemistry [1]
Submit
Validation data
Reference
Comment
Report error
- Product number
- sc-5280 - Provider product page

- Provider
- Santa Cruz Biotechnology
- Proper citation
- Santa Cruz Biotechnology Cat#sc-5280, RRID:AB_672929
- Product name
- Anti-XRCC5
- Antibody type
- Monoclonal
- Antigen
- Recombinant full-length protein
- Reactivity
- Human
- Host
- Mouse
Submitted references Parvovirus minute virus of mice induces a DNA damage response that facilitates viral replication.
Ku86 represses lethal telomere deletion events in human somatic cells.
The Ku protein complex interacts with YY1, is up-regulated in human heart failure, and represses alpha myosin heavy-chain gene expression.
Regulation of telomere length and suppression of genomic instability in human somatic cells by Ku86.
Ku heterodimer binds to both ends of the Werner protein and functional interaction occurs at the Werner N-terminus.
Adeyemi RO, Landry S, Davis ME, Weitzman MD, Pintel DJ
PLoS pathogens 2010 Oct 7;6(10)
PLoS pathogens 2010 Oct 7;6(10)
Ku86 represses lethal telomere deletion events in human somatic cells.
Wang Y, Ghosh G, Hendrickson EA
Proceedings of the National Academy of Sciences of the United States of America 2009 Jul 28;106(30):12430-5
Proceedings of the National Academy of Sciences of the United States of America 2009 Jul 28;106(30):12430-5
The Ku protein complex interacts with YY1, is up-regulated in human heart failure, and represses alpha myosin heavy-chain gene expression.
Sucharov CC, Helmke SM, Langer SJ, Perryman MB, Bristow M, Leinwand L
Molecular and cellular biology 2004 Oct;24(19):8705-15
Molecular and cellular biology 2004 Oct;24(19):8705-15
Regulation of telomere length and suppression of genomic instability in human somatic cells by Ku86.
Myung K, Ghosh G, Fattah FJ, Li G, Kim H, Dutia A, Pak E, Smith S, Hendrickson EA
Molecular and cellular biology 2004 Jun;24(11):5050-9
Molecular and cellular biology 2004 Jun;24(11):5050-9
Ku heterodimer binds to both ends of the Werner protein and functional interaction occurs at the Werner N-terminus.
Karmakar P, Snowden CM, Ramsden DA, Bohr VA
Nucleic acids research 2002 Aug 15;30(16):3583-91
Nucleic acids research 2002 Aug 15;30(16):3583-91
No comments: Submit comment
Supportive validation
- Submitted by
- per
- Main image

- Experimental details
- Western blot analysis of antibody specificity using a routine panel composed of IgG/HSA-depleted human plasma and protein lysates from selected human tissues and cell lines.
- Validation comment
- Single band corresponding to the predicted size in kDa (+/-20%).
- Primary Ab dilution
- 1:500
- Secondary Ab dilution
- 1:7000
- Lane 1
- Marker [kDa]: 230, 110, 82, 49.3, 32.2, 25.5, 17.6
- Lane 2
- RT-4
- Lane 3
- U-251MG sp
- Lane 4
- Human Plasma
- Lane 5
- Liver
- Lane 6
- Tonsil
- Theoretical target weight
- [kDa] 19
Supportive validation
- Submitted by
- per
- Main image
- Experimental details
- Immunohistochemical staining of human colon shows strong nuclear positivity in glandular cells.
- Validation comment
- Two independent antibodies targeting one protein yielding similar staining patterns. Staining pattern consistent with experimental and/or bioinformatic data.